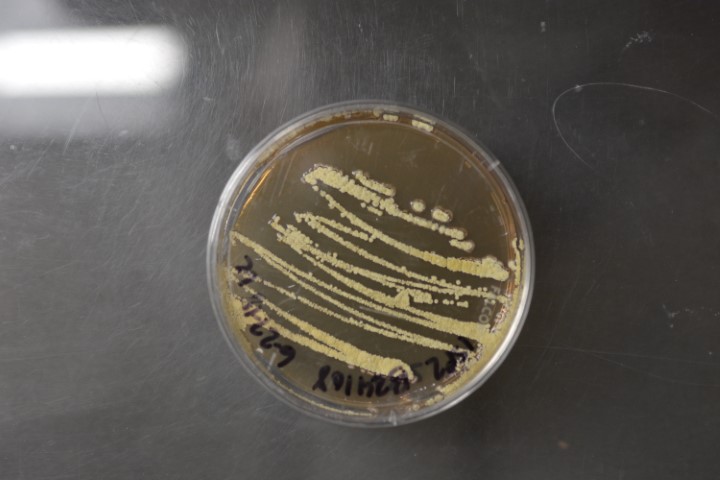

Streptomyces albus subspecies chlorinus
NRRL B-24108
Accession numbers in other collections:LW 030448
Source:Hahn,D.(Dow Agra LLC,Greenfield,IN)
Isolated from(substrate):soil
Substrate location:unknown,Lilly Research Laboratories,unknown
Genetic info:Sequence data on AMGSDB website.
Growth media:Yeast Extract-Malt Extract Agar(ISP 2)(number 10)
Optimum growth temperature:28C
Strain images:
NRRL_B-24108_10.JPG

Comments:Nomenclaturally invalid subspecies.